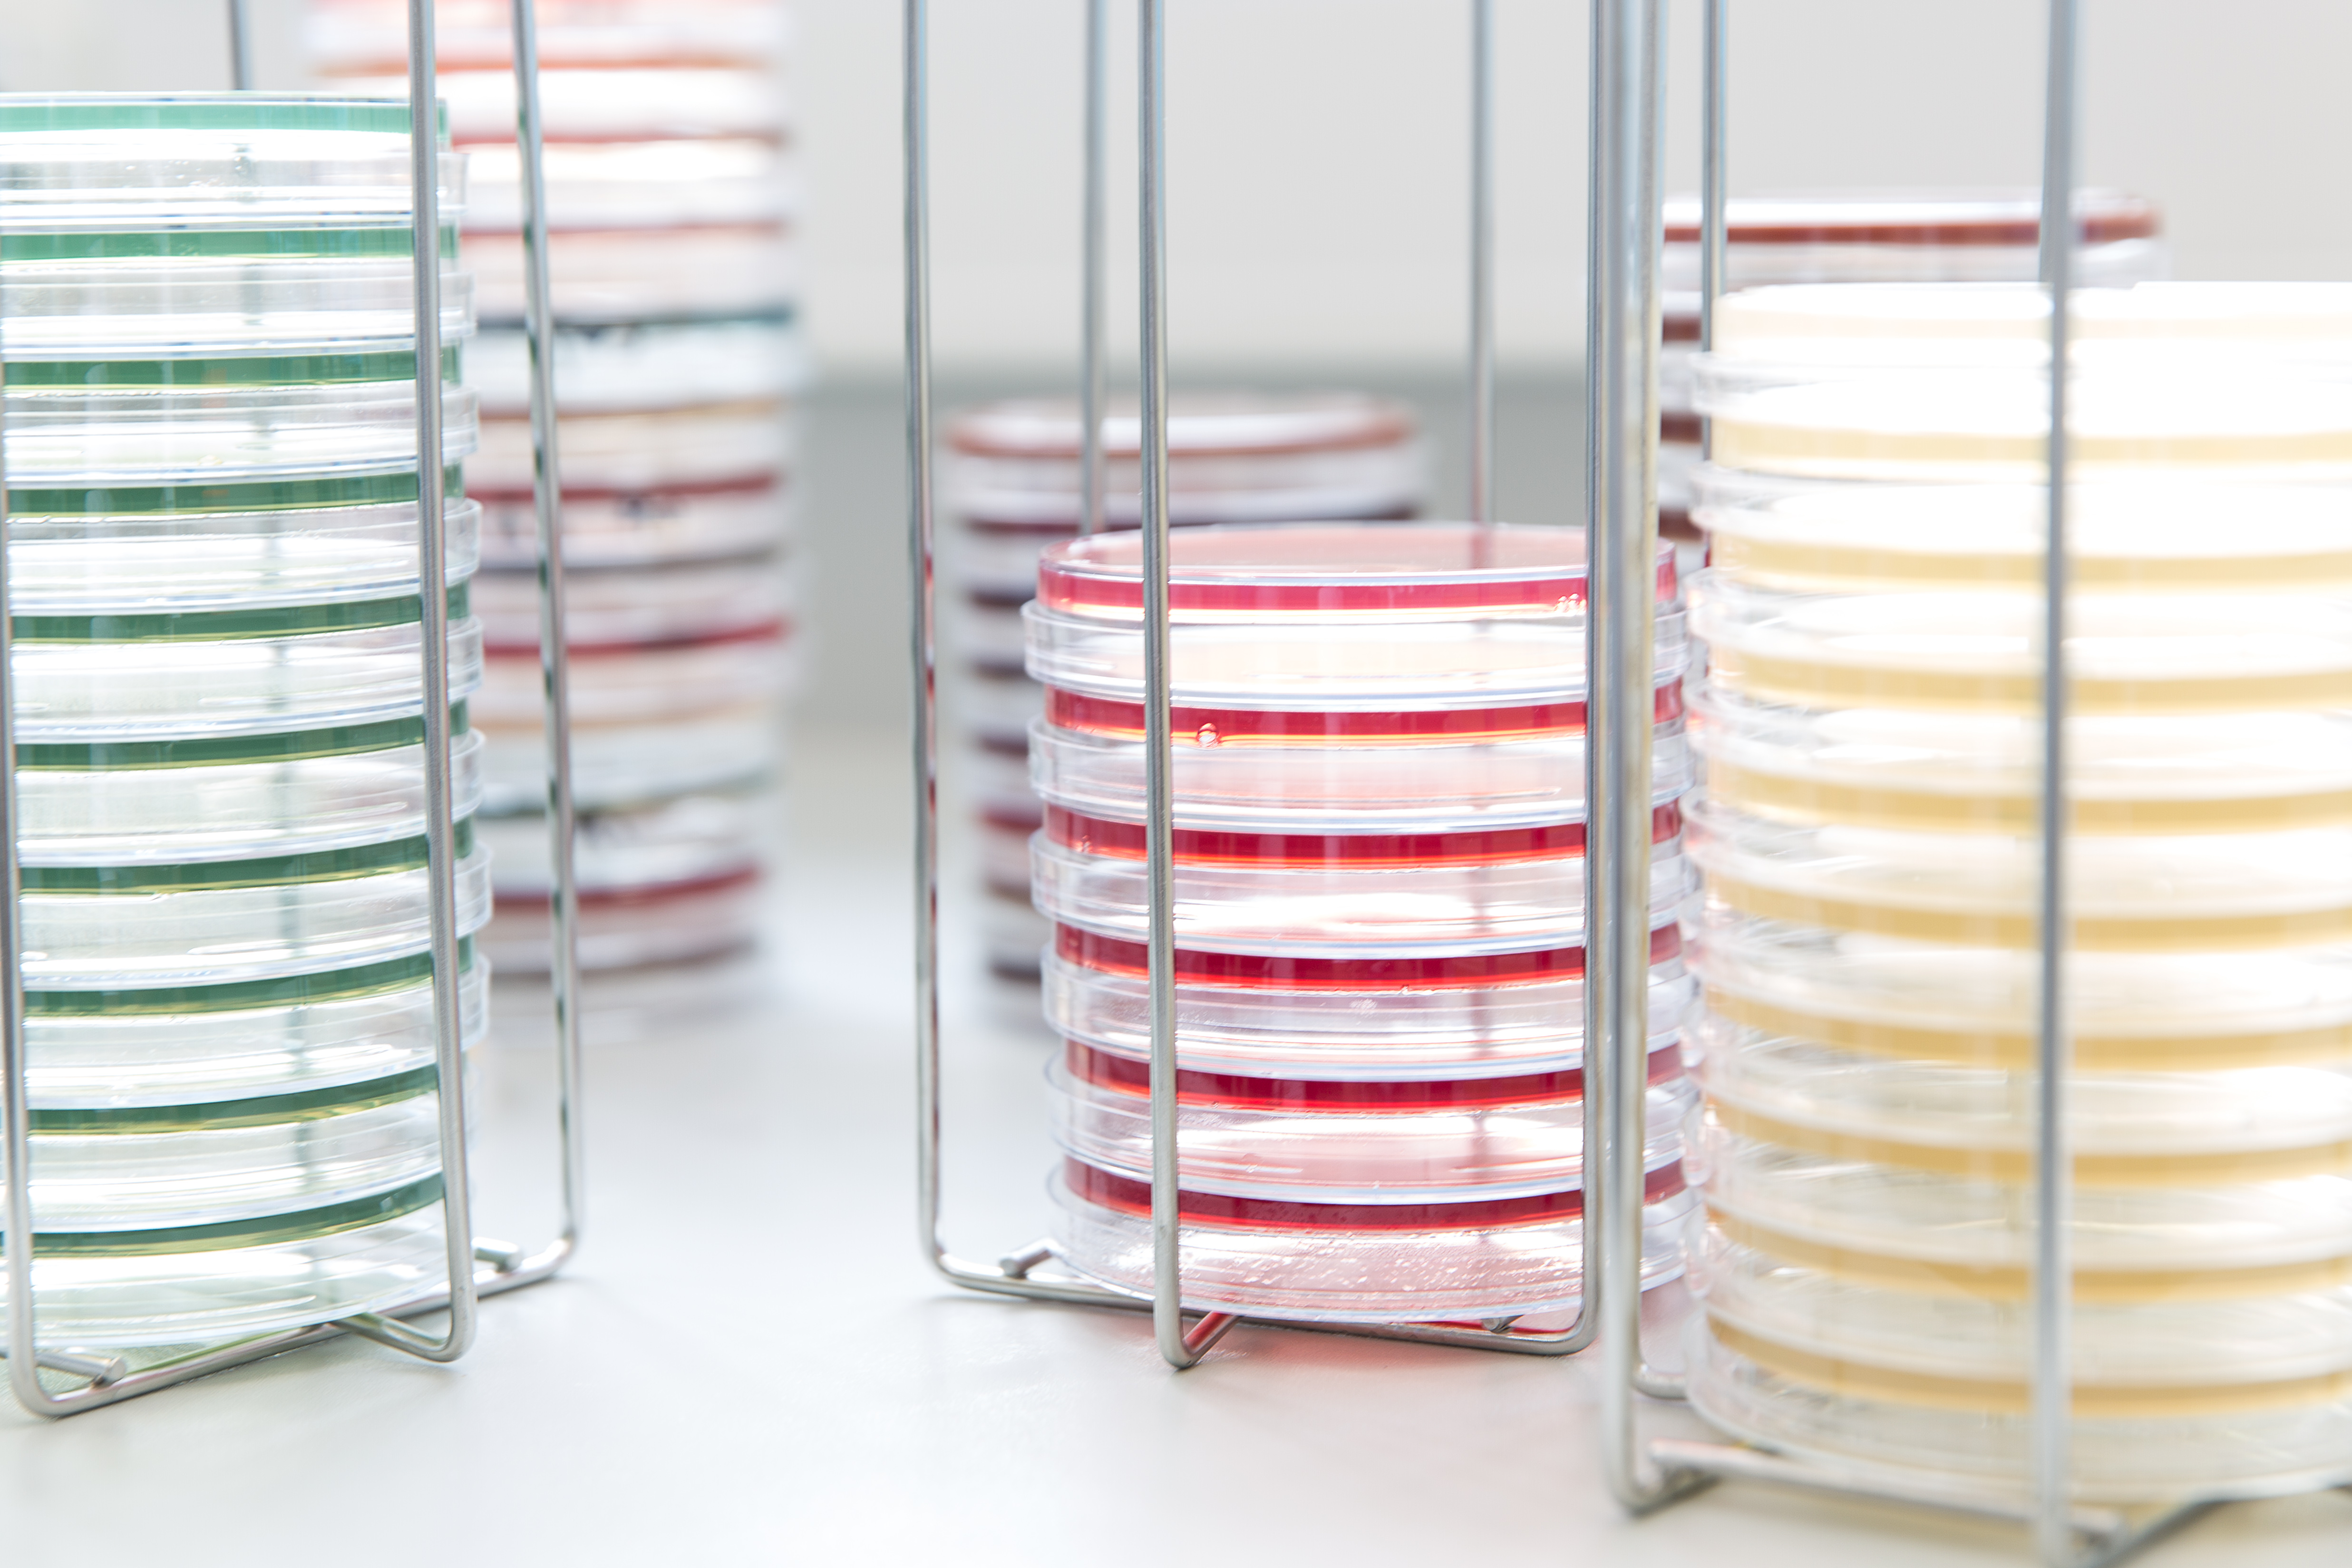
vetalab

Vetalab auf dem bpt-Kongress in Hannover
18. September 2018Fortbildungen Januar bis Mai 2019
16. Januar 2019Was ändert sich für Tierärzte durch die TÄHAV Novelle?
Mit der neuen Novelle der Tierärztlichen Hausapotheken-Verordnung (TÄHAV)
wurden die Bestimmungen zum Einsatz antibiotischer Wirkstoffe in der
Veterinärmedizin verschärft.
Um die Tierärztinnen und Tierärzte bei den notwendigen Schritten zur Umsetzung der neuen TÄHAV Novelle zu unterstützen, bietet die Online-Weiterbildungsplattform von Vetion.de (MyVetlearn.de) einen Fortbildungskurs: „Was ändert sich für Tierärzte durch die TÄHAV-Novelle“ an.
Hier gelangen Sie zur Anmeldung für die Online-Weiterbildung.
Um die Tierärztinnen und Tierärzte bei den notwendigen Schritten zur Umsetzung der neuen TÄHAV Novelle zu unterstützen, bietet die Online-Weiterbildungsplattform von Vetion.de (MyVetlearn.de) einen Fortbildungskurs: „Was ändert sich für Tierärzte durch die TÄHAV-Novelle“ an.
Hier gelangen Sie zur Anmeldung für die Online-Weiterbildung.
